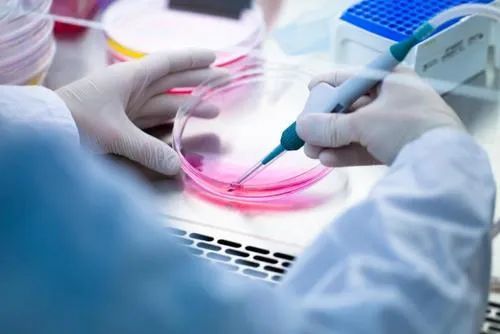
ʯô ʯʲô

糖尿病肾结石怎么排 糖尿病有肾结石会有什么后果
一、排石治疗方法综述
血糖控制
血糖的稳定是排石治疗的关键,为了降低泌尿系感染的风险,患者的血糖应控制在安全范围内。这需要我们严格遵守医生的嘱咐,调整降糖药物或胰岛素的剂量,从而有效地降低结石形成和复发的可能性。
药物排石策略
对于小于0.6厘米的结石,我们可以采用口服排石颗粒,如肾石通、金钱草冲剂等,或利尿剂如氢氯噻嗪,以促使其自然排出。
对于较大的结石,体外冲击波碎石术(ESWL)或输尿管镜碎石术(URS)是有效的治疗方法。术后需大量饮水,冲刷尿路,减少感染风险。
饮食调整建议
严格控制高草酸、高嘌呤食物的摄入,如、动物内脏和浓茶等。
采用低盐低钙饮食,减少乳制品的摄入,避免钙离子浓度升高。
增加膳食纤维的摄入,如多吃蔬菜、粗粮等,以促进代谢平衡。
手术治疗选项
对于大于2.0厘米的结石或嵌顿的结石,经皮肾镜碎石术(PCNL)或开放手术取石是有效的治疗方法。输尿管结石则优先选择输尿管软镜碎石术(F-URS)。
二、糖尿病肾结石的潜在后果详解
泌尿系感染风险
高血糖环境为细菌繁殖提供了温床,易引发肾盂肾炎或肾积脓。一旦出现症状,如发热、腰痛、脓尿等,应立即就医,通常需要使用头孢类抗生素进行治疗。
肾功能损伤警示
长期结石梗阻可能导致肾积水,进而降低肾小球滤过率(GFR),严重时可能发展为慢性肾病(CKD)甚至终末期肾病(ESRD)。早期干预和治疗至关重要。
血尿与疼痛
结石在体内的移动可能摩擦损伤黏膜,导致血尿及肾绞痛。对于这种情况,除了使用止痛药如布洛芬外,还可能需要使用止血药物如维生素K1。
心血管风险增加
糖尿病合并肾结石的患者更容易并发高血压、动脉硬化等疾病,因此血压控制尤为重要,建议将血压控制在130/80mmHg以下。
三、注意事项提醒
定期监测
建议每3-6个月进行一次B超或CT复查,以评估结石变化和肾功能。这样可以在早期发现问题并采取相应的治疗措施。
避免自行用药
如果出现药物刺激胃部或排石不适的情况,应及时就医,由医生根据具体情况调整治疗方案。切勿自行停药或更改药物剂量。
中医辅助治疗
可以尝试食疗和针灸等方法缓解症状。但中医治疗应与西医治疗相结合,以达到最佳效果。糖尿病肾结石的管理需要多学科协作,建议在内分泌科和泌尿外科的联合指导下制定个体化方案。通过综合治疗和科学管理,我们能够有效应对糖尿病肾结石的挑战。